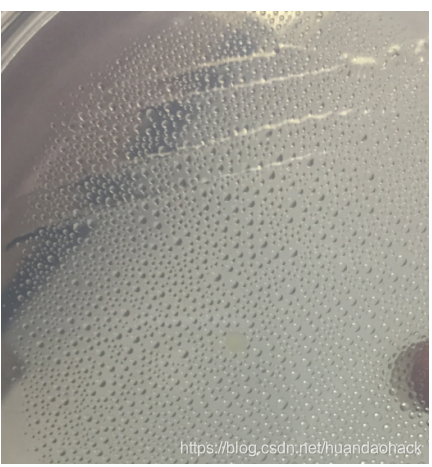

微生物大肠杆菌钝化培养
证明你没白学生物系列
作者:einyboy or alert
一、概述
实验是2020年五一期间完成的,现在才有空整理成文。微生与人类的生产密切相关,酿酒,发酵,腌渍食品,扩生素、基因克隆都离不开微生物。其中人类首次在大肠杆菌中发现了现制性内切霉,基因编辑的大门也随之打开,本实验培养的选择对象为大肠杆菌原因在于这是最常用的基因工程细菌,并且危害不大,实验相对安全。最生要的事某宝买的太贵,只好自己培养了。

二、实验目的
1.了解微生物培养基的相关成分。
2.实践无菌操作技术。
3.利用现成的琼脂平板培养基从土壤中培养微生物的方法。
三、材料
1.LB培养基:

配置方案一:
单独买来配置,价格贵,本实验没采用,优点是什么时间配置都行,保质期长。

配置方案二:直接买LB培养基,便宜方便。本实现采用方案。

土壤:小区里多得很

小可乐瓶:

四、操作过程
1.土壤中的细菌提取。
课本稀释途布平板方法
1)灭菌锅灭锅对实验试管进行灭菌,这东西对贫困山区来说贵。

2)细菌稀释,简单来讲就像是你喝的啤酒用水希释,这样在最后的试管里被稀了10^6培,液体里细菌就少很多了(这是实验室里大神的做法,费劲)


3)涂布培养

4)恒温培养
放恒温培养箱中37度恒温培养,恒温培养箱这东西真的适合拿来教学?

本人独创稀释平板法
1)用沸水煮一下或95%酒精洗一下就行,95%酒精很便宜,药店买。
2)小可乐瓶过量水饿养稀释法

可乐瓶中使用过量水直接稀释,静置2天,土壤中的营养不断消耗,细菌就没吃的了,自然在可乐瓶中上清液细菌就少。
5)恒温培养
拿起你家的吹风机吹个5-10分钟,直到培养皿该出现水蒸汽凝结的水珠就行,或你拿个不漏水的袋子装着培养皿来个40度的水浴也行。如下
放个24小时就有菌落出现了。
五、结果



























 被折叠的 条评论
为什么被折叠?
被折叠的 条评论
为什么被折叠?










